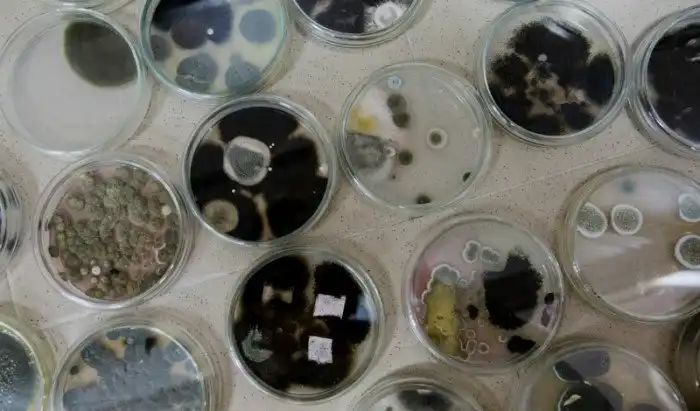

Плесень в доме
Плесневой грибок, или еще проще плесень, считается самым распространенным типом грибка в мире. Ему не нужно ничего, кроме влаги и потому наши квартиры и дома, где вода льется из нескольких кранов, а трубы часто протекают, подходят просто идеально. Некоторые формы плесени потенциально опасны не только для жилища, но и для человека. Почитайте, как понять, что вредный грибок уже завелся у вас и что с ним теперь делать.
Протечка воды
Проблемы с трубами встречаются даже в новых домах. Обратите внимание, не просачивается ли вода у вас на стене или даже на потолке — если что-то такое и в самом деле есть, то плесень почти наверняка растет где-то в доме.
Запах
Неприятный, зачастую даже едкий запах плесени возникает очень быстро. Стоит пройти по всем комнатам и найти источник: скорее всего, основной очаг плесени находится именно там. Ничего не видите? Придется снимать обои. В особо неприятных случаях плесень может расти даже внутри стен.
Запотевшие окна
Конденсат выступает на окнах при повышенной влажности. Многие люди просто привыкают видеть окна постоянно запотевшими и не обращают на это внимание — совершенно зря, поскольку именно такая ситуация характерна для домов, где уже завелась плесень.
Зуд в глазах и отеки горла
Зимой такие признаки проще всего списать на легкую простуду. Однако, если зуд и покраснение глаз сопровождаются болью в горле и ринитом, притом все это активизируется дома, то причиной может быть возникшая аллергия на плесень.
Респираторные заболевания
Примерно то же самое относится и к появлению тяжелого кашля и хрипов в груди. Некоторые виды плесени обладают повышенной токсичностью, что приводит к развитию астмы.
Боль в груди
Ощущение постоянного давления в груди также является одним из главных признаков аллергической реакции на плесень. Простуда уже давно прошла, а грудь все равно «давит»? Проверьте весь дом — возможно, дело в плесени.
Возвращения врага
Регулярная проверка мест, откуда была удалена плесень, строго обязательна. Уничтоженная колония плесени под кухонной раковиной, к примеру, вернется почти наверняка.
Стоит ли вызывать спецов
Как вы уже поняли из текста выше, плесень вполне может вызывать сильные аллергические реакции. Если у вас они проявляются, то лучше будет вызывать специальную службу и не подвергать свое здоровье риску. Если проблем со здоровьем нет, то можно попробовать избавиться от грибка самостоятельно.
Самостоятельная работа
Без защитных средств убирать плесень не стоит. Респиратор, очки, перчатки — этого будет достаточно. Раствор для уничтожения плесени готовить проще простого: разведите хлорный отбеливатель с водой в пропорции 1:3, затем жесткой щеткой тщательно удалите все пятна плесени с зараженного участка. Его затем нужно будет промыть еще раз и аккуратно высушить феном.